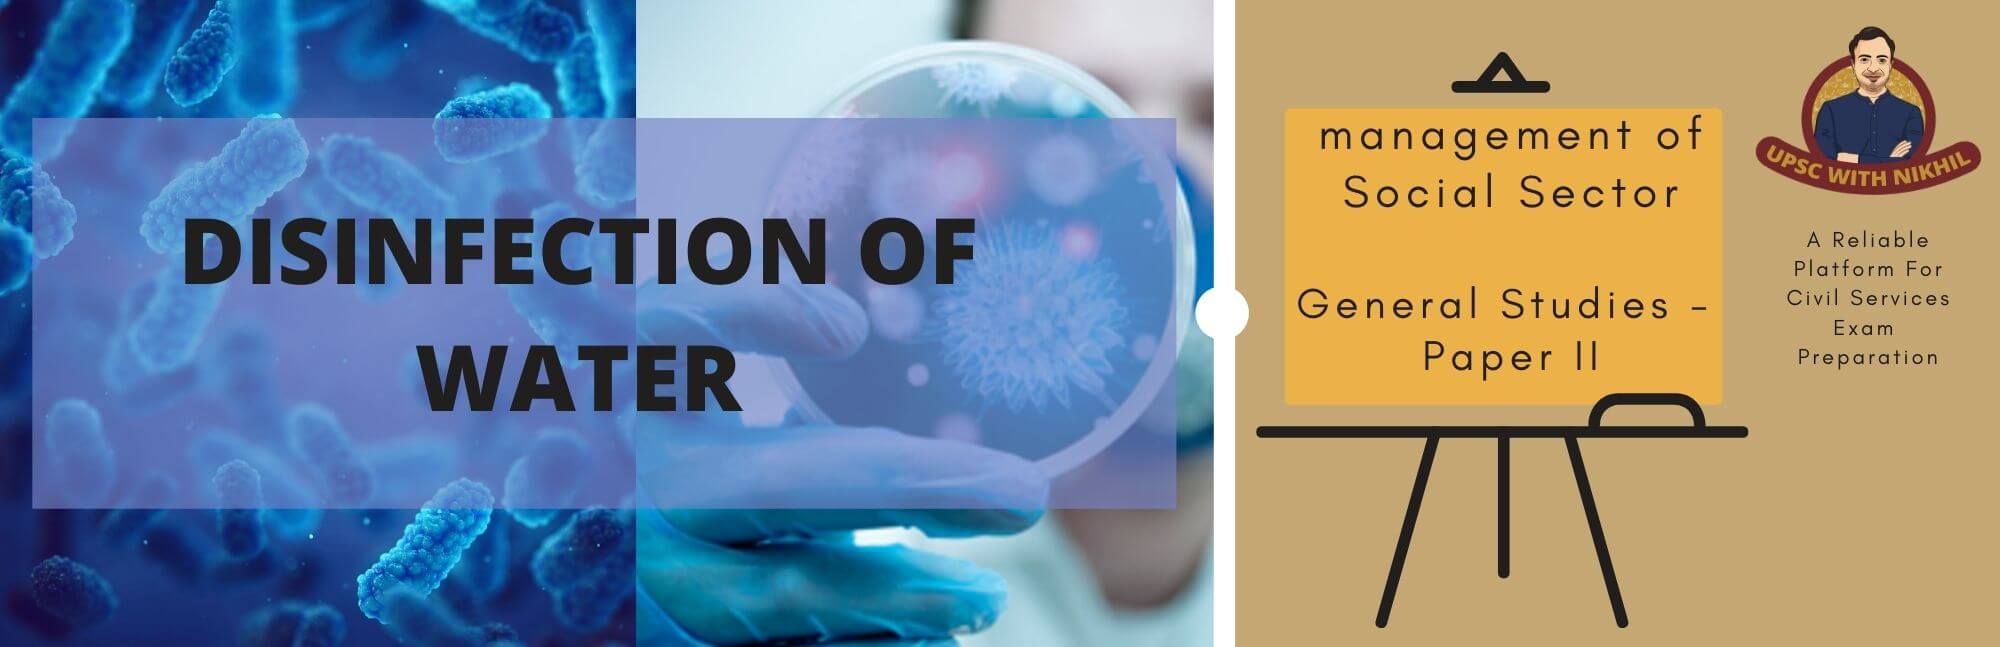
Disinfection of Water

The International Whaling Commission (IWC) is the global body charged with the conservation of whale...
Read MoreUNISDR was created in December 1999. The successor to the secretariat of the International Decade fo...
Read MoreAccording to Convention of Biological Diversity, Environmental Impact Assessment (EIA) is a process ...
Read MoreThe United Nations Development Programme (UNDP) is a United Nations’ global development networ...
Read MoreDisinfection is accomplished both by filtering out harmful micro-organisms and also by adding disinf...
Read More" HOWEVER GOOD A CONSTITUTION MAY BE, IF THOSE WHO ARE IMPLEMENTING IT ARE NOT GOOD, IT WILL PROVE T...
Read MoreThe five following parameters are basic to life within aquatic systems. Impairments of these can be ...
Read MoreThe UN is the largest (193 members), most familiar, and most internationally represented and most po...
Read MoreITU (headquartered in Geneva) is the United Nations specialized agency for information and communica...
Read MoreUNIDO (headquartered in Vienna) is the specialized agency of the United Nations that promote...
Read MoreThe World Trade Organization (WTO) is the only global international organization dealing with the ru...
Read MoreThe World Bank (collective name of IBRD and IDA) is a vital source of financial and technical assist...
Read More